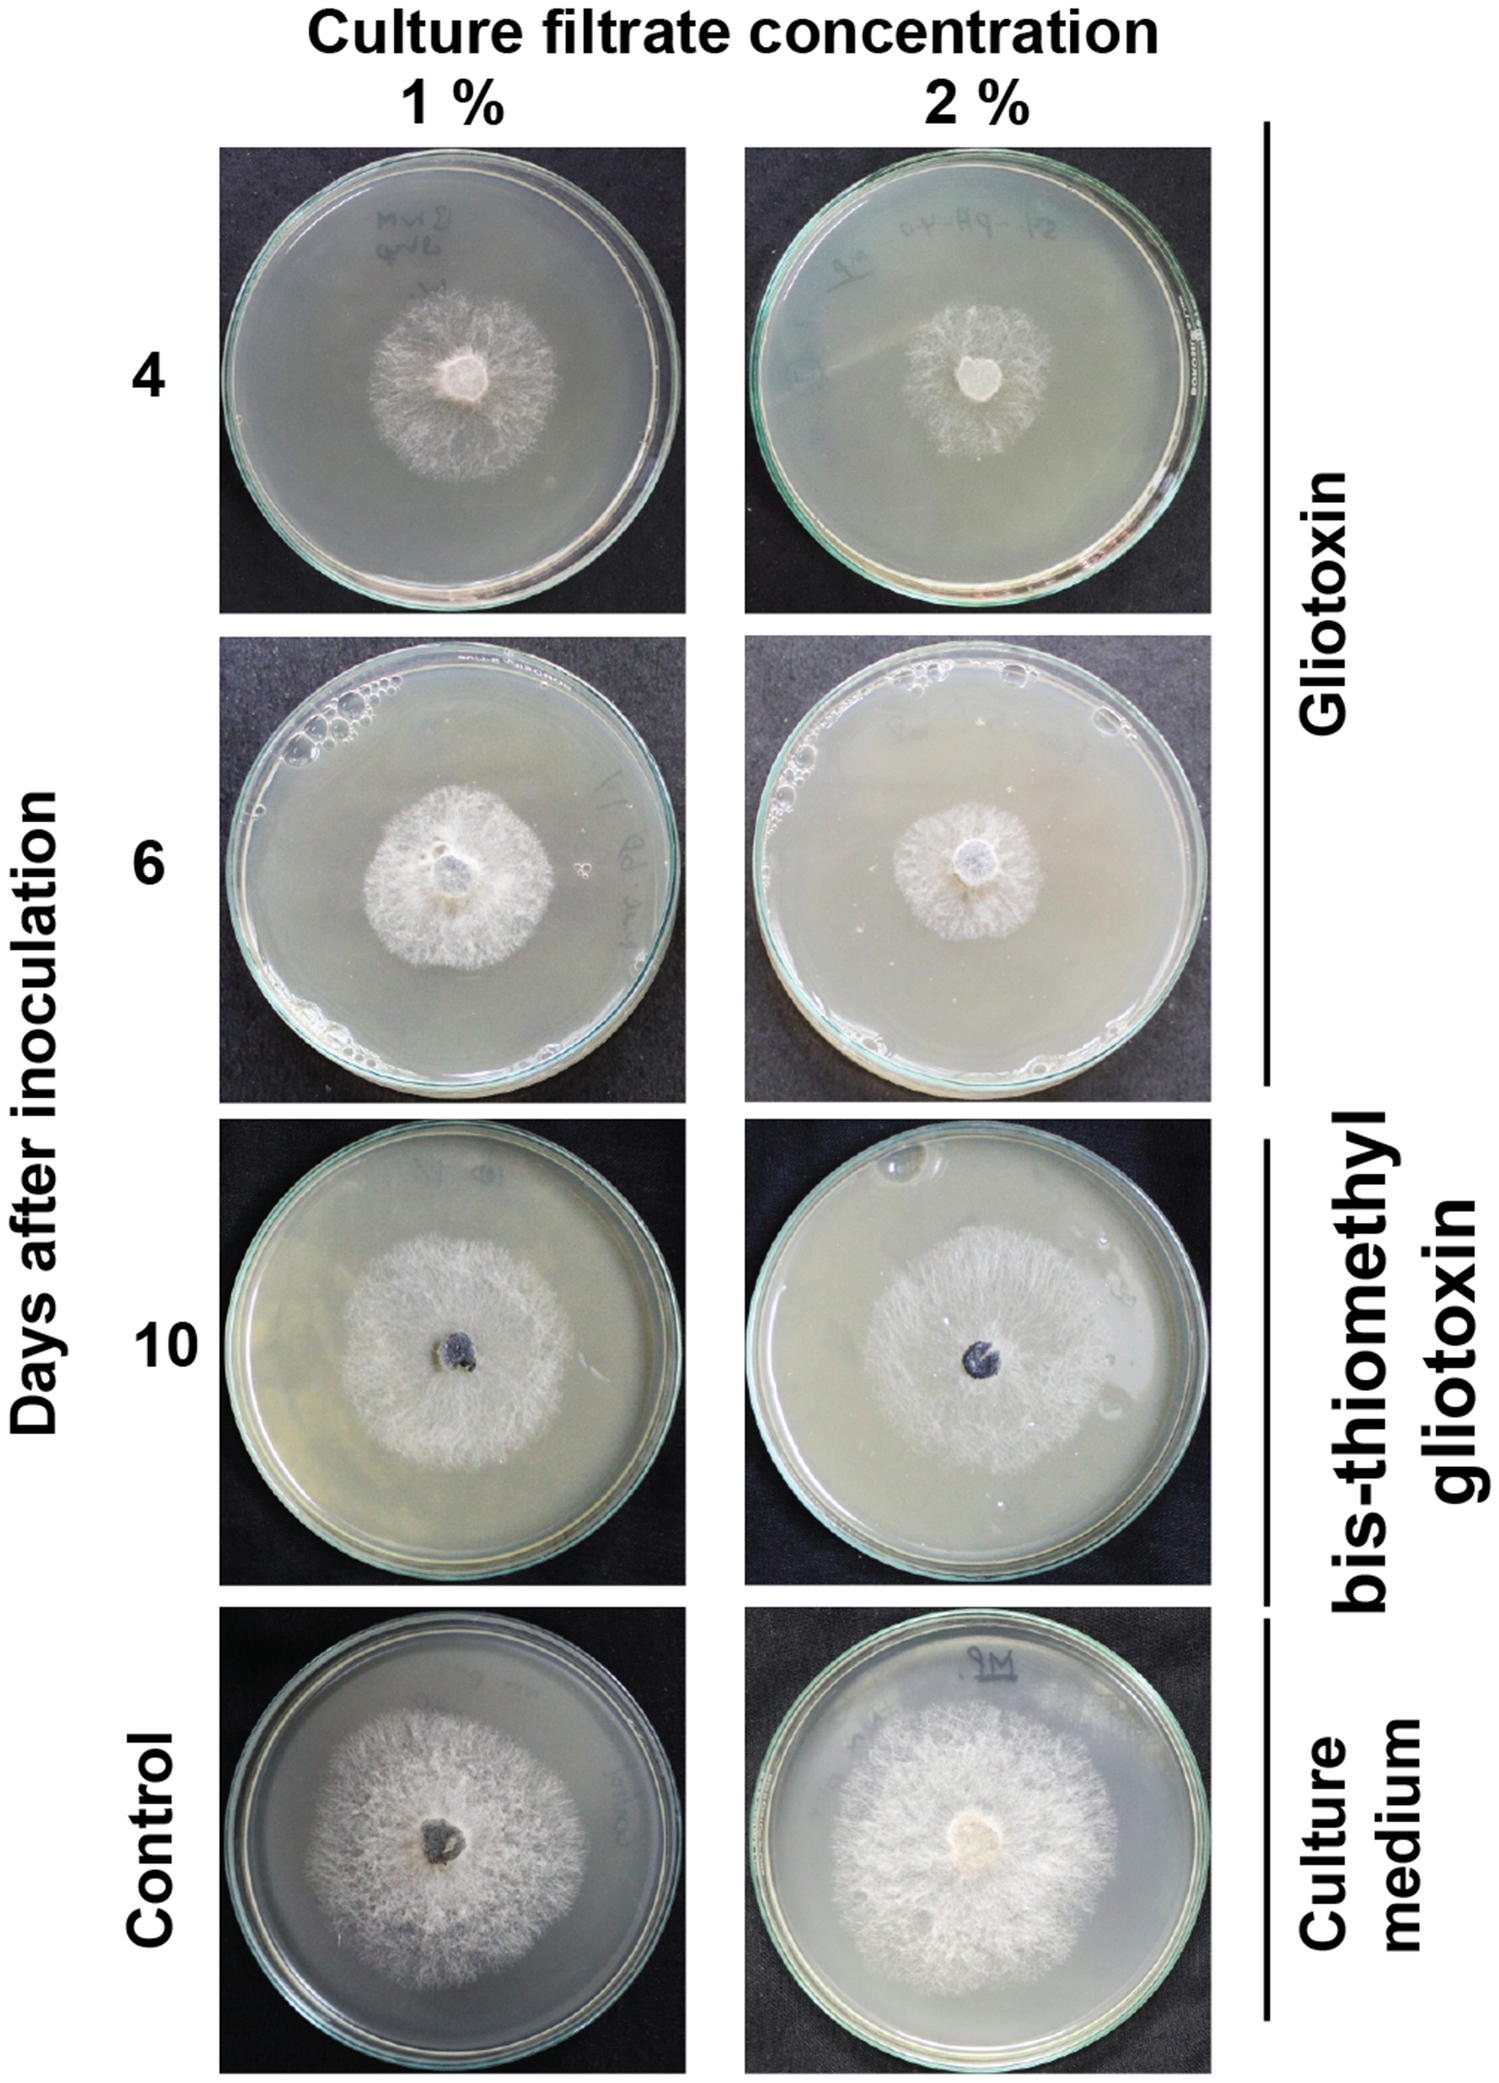
Figure 5

Figure 5
Antifungal activity of gliotoxin and bis-thiomethyl gliotoxin. PDA medium was amended with 4th and 6th day old culture filtrate (containing gliotoxin) and 10th day old culture filtrate (containing bis-thiomethyl gliotoxin) of T. virens and inoculated with M. phaseolina. Control consists of PDA amended with Weindling medium. The mycelial growth was measured.
